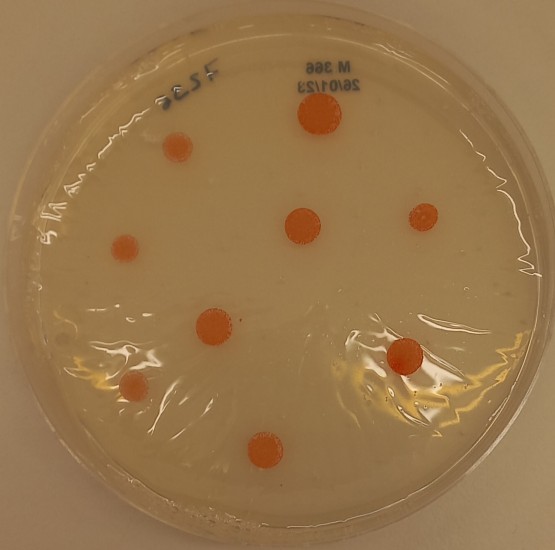
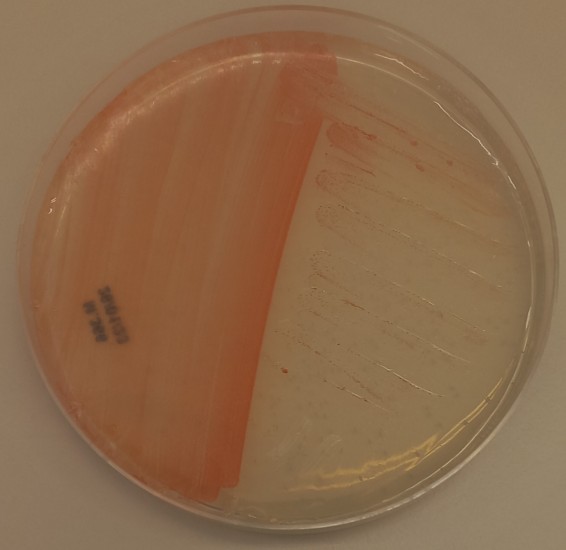

| Name |
Halorubrum californiense Pesenti et al. 2008 |
|
| Strain designation | SF3-213 |
|
| Other collections | DSM 19288; JCM 14715 |
|
| Access in situ (sampling data) | Source: Crystallizer pond at the Cargill Solar Salt Plant Country of access: United States Locality, State of access: Newark (California) Date of access: Before 01-01-1997 |
|
| Isolation data | Isolated by: Litchfield, C. Date of isolation: 01-01-1997 |
|
| History | CECT, 2007 < A. Ventosa, Univ. Sevilla, Spain < C. Litchfield |
|
| Growth conditions | Culture media: 366 Growth temperature (in °C): 37 Incubation time: 7d Atmospheric needs: aerobic Cultivation conditions for CECT strains |
|
| Restrictions | Risk group: 1 CECT MTA |
|
| Genetic data | G+C mol%: 69.4 mol% 16S rRNA sequence: EF139654 Complete genome sequence: GCA_000336875.1 |
|
| Delivery | | Freeze-dried culture | | Acticult® 3R | | Active culture rate A | | Genomic DNA |
Tarifas de presentaciones |
|
 Temperature: 37.0°C CECT Culture medium 366: R2A 25% salts (20 days) Temperature: 37.0°C CECT Culture medium 366: R2A 25% salts (14 days) |
| La CECT sigue estándares de calidad para garantizar la viabilidad, pureza y autenticidad de las cepas que conserva. La información mostrada en esta ficha procede de diversas fuentes. Algunas de las propiedades no han sido necesariamente contrastadas por la CECT |